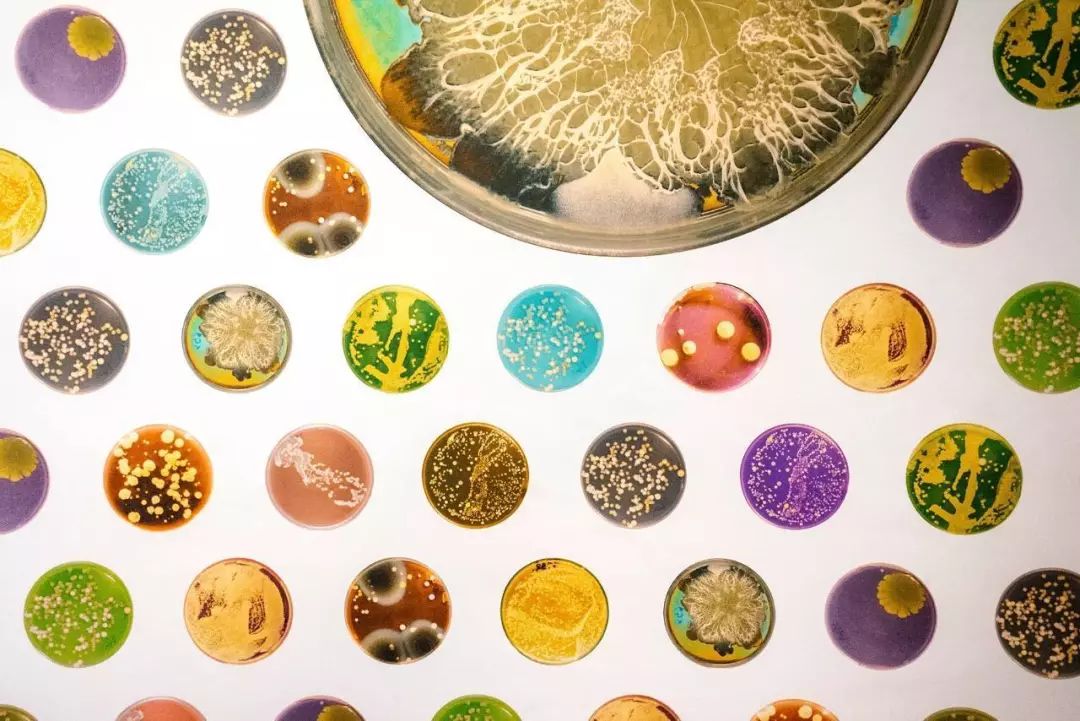
多菌种混合发酵优于单一菌种发酵,微生物多样性是导致白酒风味物质

白酒微生物

多菌种混合发酵优于单一菌种发酵,微生物多样性是导致白酒风味物质
图片尺寸1080x721
"如果谁能把白酒微生物研究透了,能拿诺贝尔
图片尺寸1000x1333
酿酒里面的微生物
图片尺寸1000x750
丰富的酿酒微生物
图片尺寸1024x649
中国白酒酿造过程中的神秘大军微生物大军
图片尺寸960x600
这就是传说中的茅台酿酒微生物
图片尺寸1000x582
酱酒科普精选:白酒酿造过程中,每种微生物都起什么作用?
图片尺寸1278x790
酒里乾坤,为什么世界只有一个泸州?|微生物|白酒
图片尺寸500x375
微生物菌种检测
图片尺寸660x400
一种清香型白酒酿造过程中微生物群落结构的分析方法与流程
图片尺寸533x421
因此,加强对酿酒微生物种类及作用的认识,有助于理解白酒的发酵.
图片尺寸1024x576
为何酱香型白酒的制曲讲究在端午?_微生物_大曲_高温
图片尺寸1080x676
主要酿酒微生物
图片尺寸1280x854
白酒与微生物的故事
图片尺寸720x512
丰富的酿酒微生物
图片尺寸500x323
玺悦东方|一篇文章读懂白酒各种酒曲的区别_酿酒_微生物_原料
图片尺寸594x443
好酒来自好曲,好曲就离不开这些微生物,你知道哪一种呢?
图片尺寸640x407
白酒与微生物的故事
图片尺寸8000x4500
主要酿酒微生物
图片尺寸2029x1080
那些看不见的小东西决定了一款白酒风味_微生物_生产_酿酒
图片尺寸1200x801